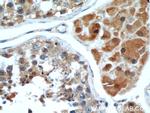
WBP2 Antibody in Immunohistochemistry (Paraffin) (IHC (P))
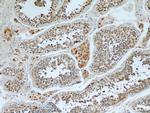
WBP2 Antibody in Immunohistochemistry (Paraffin) (IHC (P))

Search
Proteintech
WBP2 Polyclonal Antibody
{{$productOrderCtrl.translations['antibody.pdp.commerceCard.promotion.promotions']}}
{{$productOrderCtrl.translations['antibody.pdp.commerceCard.promotion.viewpromo']}}
{{$productOrderCtrl.translations['antibody.pdp.commerceCard.promotion.promocode']}}: {{promo.promoCode}} {{promo.promoTitle}} {{promo.promoDescription}}. {{$productOrderCtrl.translations['antibody.pdp.commerceCard.promotion.learnmore']}}
产品信息
12030-1-AP
种属反应
已发表种属
宿主/亚型
分类
类型
抗原
偶联物
形式
浓度
规格
纯化类型
保存液
内含物
保存条件
运输条件
产品详细信息
Immunogen sequence: MALNKNHSE GGGVIVNNTE SILMSYDHVE LTFNDMKNVP EAFKGTKKGT VYLTPYRVIF LSKGKDAMQS FMMPFYLMKD CEIKQPVFGA NYIKGTVKAE AGGGWEGSAS YKLTFTAGGA IEFGQRMLQV ASQASRGEVP SGAYGYSYMP SGAYVYPPPV ANGMYPCPPG YPYPPPPPEF YPGPPMMDGA MGYVQPPPPP YPGPMEPPVS GPDVPSTPAA EAKAAEAAAS AYYNPGNPHN VYMPTSQPPP PPYYPPEDKK TQ (1-261 aa encoded by BC010616)
靶标信息
The globular WW domain is composed of 38 to 40 semiconserved amino acids shared by proteins of diverse functions including structural, regulatory, and signaling proteins. The domain is involved in mediating protein-protein interactions through the binding of polyproline ligands. WBP2 is a WW domain binding protein, which binds to the WW domain of Yes kinase-associated protein by its PY motifs. The function of this protein has not been determined.
仅用于科研。不用于诊断过程。未经明确授权不得转售。
生物信息学
蛋白别名: unnamed protein product; WBP-2; WBP2; WW domain-binding protein 2
基因别名: DFNB107; GRAMD6; WBP-2; WBP2
UniProt ID: (Human) Q969T9, (Mouse) P97765, (Rat) Q8R478
Entrez Gene ID: (Human) 23558, (Mouse) 22378, (Rat) 192645